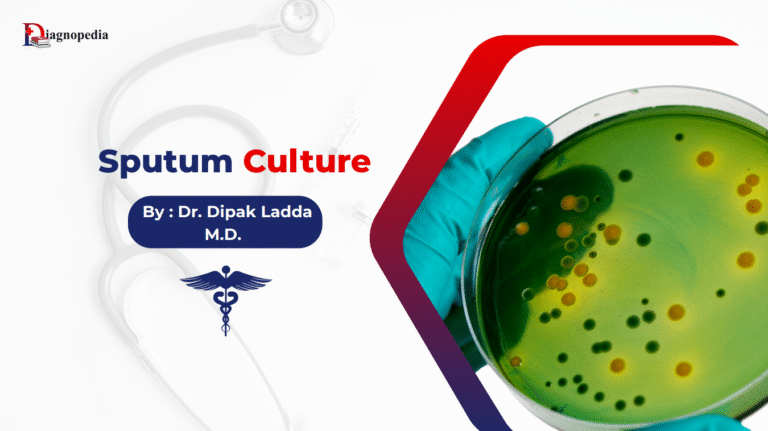
Sputum Culture Test

Library
Explore curated doctoral theses and clinical presentations— organized for clarity, built for quick reference, and trusted by the medical community.
Start Exploring 850+ Medical Topics
Ex: Cholesterol
Featured Topics
Overview The Sputum Culture Test is a vital microbiological investigation used to diagnose respiratory infections by detecting and identifying organisms...

Overview Somatostatin receptors (SSTRs) are G-protein–coupled receptors that mediate the biological actions of somatostatin, a peptide hormone known for inhibiting...

Overview Somatostatin is a naturally occurring peptide hormone with powerful inhibitory effects on multiple hormonal and digestive functions. Discovered in...

Overview The Sodium Test is a critical diagnostic tool used to evaluate serum and urine sodium levels, helping in the...

Overview The SMRP Test measures the levels of Soluble Mesothelin-Related Peptides (SMRP) in the blood. These peptides are fragments of...












